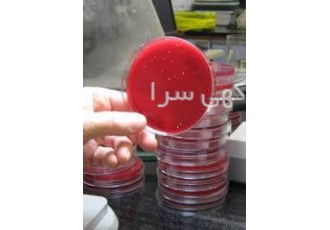

فروش انواع محیط کشت میکروبیولوژی و بیولوژی فروش محیط کشت های 100 گرمی
فروش محیط کشت های 100 گرمی و 500 گرمی ازکمپانی مرک ، کیولب و شارلوو...... و سایرکمپانی های درخواستی
فروش انواع محیط کشت های سلولی و میکروبیولوژی
معرفی برخی از محیط کشت موجود:
- بلاد اگار- BLOOD AGAR- براٍث - اسیلوس سرئوس اگار- BACILLUS SEREUS AGAR - برلیانت گرین اگار- BGA-
دکستروز اگار- دزوکسی سیترات اگار- مکانکی اگار- ام ار اس برات - نوترینت اگار- اورنج سرم اگار- پلانت کانت اگار- SS AGAR - تریبسین پودر- اس اس اگار- سلنیت سیستیین برات – TSA - تی اس بی اگار – محیط کشت برلیانت گرین بایل براث –
محیط کشت تریپتون واتر- محیط کشت تریپل شوگر آیرون آگار- محیط کشتSSسالمونلا شیگلا آگار – محیط کشتSIM مدیوم –
محیط کشت اوره براث – محیط کشتEMB ائوزین متیلن بلو آگار – محیط کشت سیتریماید آگار- تریبسین محلول
فروش انواع محیط کشت میکروبی و سلولی از کمپانی های معتبر
شرکت مهندسی پزشکی سدید تجهیز طوبی
تلفکس : 88097... [نمایش کامل] - 021
ایمیل: sadid.t... [نمایش کامل]
در صورتیکه محل مراجعه مکانی غیرعمومی و برای شما ناشناخته است، حتی المقدور از رفتن به محل خودداری کنید یا حتماً با یک همراه مراجعه کنید.
اگر احساس میکنید کالا یا خدمات ارائه شده در آگهی تناسبی با قیمت آن ندارد، مثلاً غیرمعقول ارزانتر است، احتیاط کنید و آگهی را به ما گزارش دهید.
اگر در محتوای آگهی یا حین مکالمه و ارتباط با آگهیدهنده به مواردی مشکوک شدید، از آن آگهی صرفنظر کرده و آن را گزارش کنید.
چنانچه احساس میکنید آگهیدهنده از شما درخواست غیرمعقول و غیرموجه دارد، از آن آگهی صرفنظر کرده و آن را گزارش دهید.
آگهیهای ویژه



آگهیهای مشابه
- فروش و واگذاری مجوز واردات موز 🍌 | بدون نیاز به رفع تعهد ارزیاستان آذربایجان غربیفرصتی استثنایی برای فعالان حوزه واردات! 🚀 فروش و واگذاری مجوز واردات موز، به …
- مهندسی و طراحی فروش و بازاریابیاستان البرزشرکت پیشرو صنعت هونامیک برنامه ریزی بازاریابی و فروش شامل بخش بندی هدف گذاری …
- فروش انواع اسانس ها و رنگهای خوراکیاستان تهرانبا سلام بازرگانی شیمیایی ایلیا شیمی گستر آترین : واردکننده و تأمین کننده ی مواد …
- گوگرد ، شیمیایی ، مواد شیمیاییاستان تهرانفروش مواد شیمیایی وارداتی و داخلی گوگرد پرکلرین سود پرک سود سوزآور کاستیک سودا …
- خرید کالاهای تولیدی و تولیدات هنری شما و فروش مستقیماستان تهرانکالای تولیدی و هنر خود را ارزان نفروشید. - از کلیه تولید کنندگان و هنرمندان …